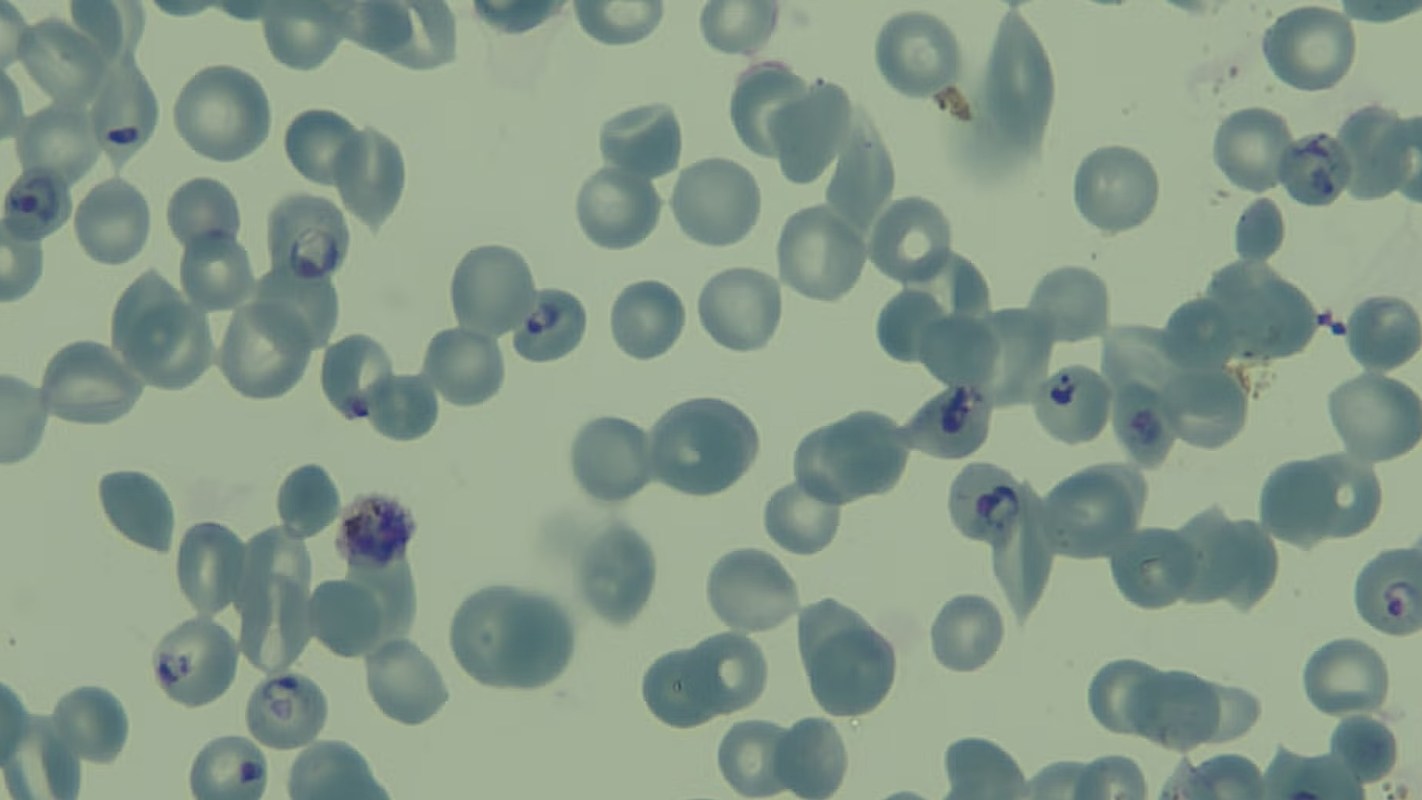

Malaria researchers have just made a breakthrough that could transform how we fight one of the world's deadliest diseases. Scientists at Harvard T.H. Chan School of Public Health have mapped the essential genes of Plasmodium knowlesi, a parasite responsible for malaria in humans. This discovery could open new doors to more effective treatments and help curb drug resistance, a growing challenge in malaria prevention.
With 249 million malaria cases worldwide each year, leading to approximately 608,000 deaths, this discovery is a huge leap forward. P. knowlesi is an emerging public health threat in Southeast Asia, and until now, researchers lacked a complete understanding of the genes necessary for its survival in human blood cells.
Using a cutting-edge genetic approach called transposon mutagenesis, scientists were able to pinpoint which genes are critical for the parasite's growth — providing a road map for new, more effective drugs.
|
Would you swallow a robot pill to improve your health? Click your choice to see results and speak your mind. |
"Emerging drug resistance to the small number of antimalarial drugs is a growing problem," said Manoj Duraisingh, one of the study's lead authors. "This map will be an invaluable resource to help researchers combat one of the leading causes of infectious disease death around the world."
So why is this such a big deal? Because understanding the parasite at the genetic level gives scientists a major advantage in tackling malaria at its source. This knowledge could lead to better drug designs that target weak points in the parasite's genetic code — helping to reduce the risk of resistance before it even begins.
What's more, the study's findings also shed light on another major malaria-causing parasite, Plasmodium vivax, which has been notoriously difficult to study because of its inability to be cultured in lab conditions. By understanding P. knowlesi, researchers are gaining critical insights into P. vivax, bringing them one step closer to better treatments for all forms of malaria.
This discovery is also timely, given that global warming is creating ideal conditions for the spread of malaria. Rising temperatures and shifting rainfall patterns are expanding mosquito habitats, allowing malaria-carrying insects to thrive in new regions. As health experts warn of an increase in mosquito-borne diseases, breakthroughs like this offer hope in the fight against their spread.
As governments and organizations work to combat malaria, scientific advances like this could be game-changers. By understanding the parasite's genetic blueprint, researchers are paving the way for more targeted, effective treatments — bringing us closer to a future when malaria is no longer a major global health threat.
Join our free newsletter for weekly updates on the latest innovations improving our lives and shaping our future, and don't miss this cool list of easy ways to help yourself while helping the planet.